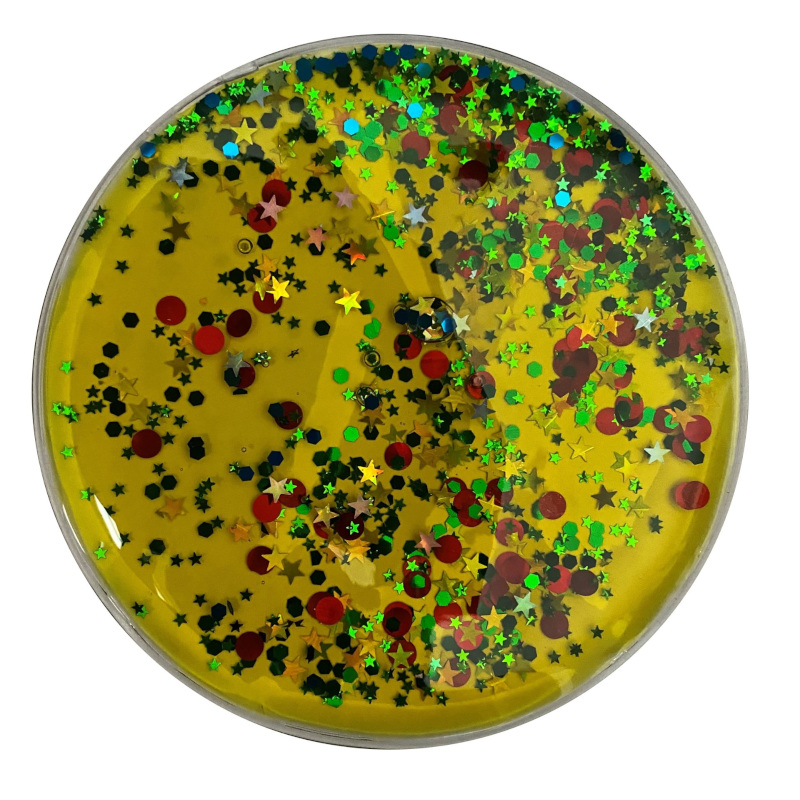
Veega mängumatid Kujundid (4tk)_

Veega mängumatid “Kujundid” (4 tk) pakuvad põnevat sensoorset elamust ja on visuaalselt haaravad. Vee ja värvilise õliga täidetud pehmete mattide sees on sätendavad osakesed, mis matile vajutades ja neid püstisesse asendisse tõstes vedeliku sees ringi liiguvad. Pehmed matid pakuvad lõbusat ja meeldejäävat viisi geomeetriliste kujundite õppimiseks. Lisaks aitab mattidega mängimine arendada motoorseid oskusi ja treenib käte osavust. Kujundid on disainitud spetsiaalselt nii, et neid oleks väikestel kätel mugav hoida ja uurida.
Komplektis on 4 kujundit:
Kolmnurk: 15 cm x 24 cm
Ruut: 15 cm x 15 cm
Ring: läbimõõt 15 cm
Ristkülik: 15 cm x 20 cm
Veega mängumatid “Kujundid” sobivad kasutamiseks ka valguslaual, kus värvid eriti hästi esile tulevad. Aseta mängumatid üksteise peale – kas märkad värvitoonides muudatusi?
Valmistatud mürgivabast pehmest ja pestavast materjalist, mis peab mängimisele vastu mitmeid aastaid.
Sobib vanusele 3+ aastat.
HOIATUS! Ei ole soovitatav alla 3-aastastele lastele. Sisaldab väikeseid detaile. Lämbumisoht.
SEE EI OLE NÄRIMISMÄNGUASI! Toodet ei tohi närida ega hammustada. Hoidke toode eemal lastest või isikutest, kes võiksid seda närida. Kui plastikust ümbris puruneb, võib selle sisu tekitada lämbumisohtu ning naha- ja silmaärritust. Sisu ei tohi neelata; selle juhtumisel pöörduge arsti poole. Vedeliku sattumisel kehale peske vastavat piirkonda sooja seebiveega.
Kasutamine peab toimuma täiskasvanu järelevalve all. Hoida eemal tulest ja tugevatest soojusallikatest.

Ostukorvis pole tooteid.
Ostukorvis pole tooteid.